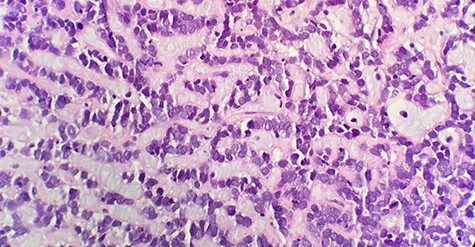
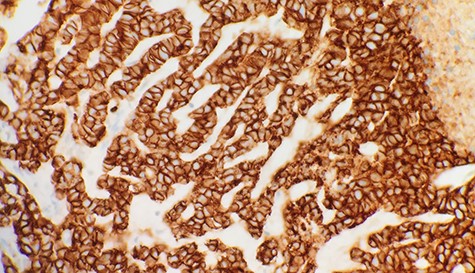

-
PDF
- Split View
-
Views
-
Cite
Cite
Breanne Gillie, Michael Kmeid, Armand Asarian, Philip Xiao, Adenoid cystic carcinoma of the breast with distant metastasis to the liver and spleen: a case report, Journal of Surgical Case Reports, Volume 2020, Issue 11, November 2020, rjaa483, https://doi.org/10.1093/jscr/rjaa483
Close - Share Icon Share
Abstract
Adenoid cystic carcinoma (ACC) of the breast is a rare malignancy, accounting for 0.1–1% of breast cancers. Histologically breast ACC is similar to ACC’s found in salivary tissue and is a triple-negative breast cancer with an uncharacteristically favorable prognosis and low incidence of metastasis. Most cases present as a painful, palpable mass; however, asymptomatic cases found on screening mammograms have also been noted. Core needle biopsy or excisional biopsy is necessary for definitive diagnosis of breast ACC. Immunohistochemistry of these cancers can differentiate breast ACC from masses with similar histology, such as invasive cribriform carcinoma and collagenous spherulosis. There is no well-established treatment guideline for ACC; however, it has been noted that reoccurrence and metastasis are noted more in cases of local resection than mastectomy.
INTRODUCTION
Adenoid cystic carcinomas (ACC) are malignancies derived from glandular tissue typically in the salivary gland, lungs and skin. It is also a relatively rare malignancy found in the breast accounting for 0.1–1% of breast cancers [1]. Breast ACCs are basal-like triple-negative breast cancers typically found in women in their fifth and sixth decades of life [2]. Despite being a triple-negative breast cancer, breast ACCs are indolent in nature and have a generally favorable prognosis due to the low incidence of spread to local lymph nodes and distant metastasis [2]. The treatment of these cancers has been somewhat controversial throughout the literature and is typically based on the grade of the tumor [2]. Although the origin of breast ACC is unknown histologically, it has a biphasic pattern consisting of myoepithelial and epithelial cells suggesting that it arises from ductal epithelium [3]. Immunohistochemically, breast ACC is typically estrogen receptor-negative, progesterone receptor-negative and does not possess the HER2 gene amplification [4]. These cancers have also been found to contain the chromosomal translocation t (6;9), resulting in an MYB-NFIB fusion gene [4].
The aims of this case report are to (i) report and review a case of a patient diagnosed with breast ACC with distant metastasis to the liver and spleen, (i) evaluate histological morphology and immunohistochemistry of the primary breast ACC and the metastatic lesions, and (iii) comment on future perspectives concerning breast ACC.
CASE REPORT
A 67-year-old female presented in early 2018 with right breast ACC previously diagnosed via diagnostic core biopsy showing invasive ACC with basaloid features in late 2017. She underwent a right modified radical mastectomy with level I lymph node dissection at this time. The pathology report demonstrated a mass measuring 3.5 × 3.5 × 2.5 with a nuclear grade of II/III. The tumor margins were negative for malignancy, and zero of nine lymph nodes showed involvement. Immunohistochemistry for the breast tumor was positive for CK5/6, p63 and MYB, and negative for ER, PR and CD11. She refused adjuvant radiation and chemotherapy at that time and was discharged. In 2019, the patient presented to the emergency department complaining of right upper quadrant abdominal pain, pruritus and darkening of the skin, urine and sclera. A computed tomography scan of the chest, abdomen and pelvis showed extensive hepatic and splenic lesions, and a bone scan showed multiple focal bony lesions suggestive of metastasis. The biopsy of the liver mass was consistent with invasive ACC (Fig. 1), and immunohistochemical stains of the liver mass showed positive mammaglobin, CDX2, CK7 and p63. MYB, CD117, CD56, PAX8, TTF1, Napsin A and CK20 stains were negative. Cells were positive for E-cadherin (Fig. 2), supporting the breast primary. The patient was diagnosed with metastatic breast adenoid carcinoma in the liver and spleen and was referred to palliative care for end of life care.
Microscopic examination reveals that tumor composed of luminal/ductal epithelial cells with variable glandular pattern and pseudolumens containing eosinophilic basement membrane material (HE x40).
Immunohistochemical stain reveals that tumor cells are positive for E-Cadherin (IHC x40).
DISCUSSION
Discussion of primary ACC of the breast has been limited by the number of cases as it accounts for only 0.1-1% of breast cancers [1]. It typically presents as a painful or painless sub-areolar mass, although it has also been described as an asymptomatic finding on screening mammogram [3, 5]. Following the recognition of irregular densities or masses on mammogram, a core needle biopsy will confirm the diagnosis [5]. The histology of breast ACC resembles salivary ACC and consists of a biphasic pattern of myoepithelial and epithelial cells arranged in several architectural patterns [4]. It typically has three growth patterns: tubular, glandular and solid, and is graded based on the number of solid components in the tumor [3]. Grade 1 involves a tubular pattern with cystic spaces, Grade 2 involves under 30% solid components and Grade 3 involves over 30% solid components [3]. A review of the literature from 1967 to 2020 yielded 1276 reported cases of breast ACC, 32 of which resulted in metastasis.
The immunohistochemical composition of these tumors mirrors that of the epithelial and myoepithelial cells. Epithelial cells are typically positive for CK7, CK8/18 and c-KIT, whereas myoepithelial cells are positive for CK5, CK5/6, CK14 and CK17 as well as p63, actin, vimentin, S-100 and EGFR [4, 6].
Our patient’s initial tumor was positive for CK5/6, p63 and MYB, and negative for ER, PR and CD117, whereas the metastatic lesions were positive for mammaglobin, CDX2, CK7 and P63, and negative for MYB, CD117, CD56, PAX8, TTF1, Napsin A and CK20. It has been suggested in the literature that preserved cell polarity, and segregated cell differentiation may offer an explanation for the lack of metastatic capacity of breast ACC and tumors grade 2 or 3 are far more likely to reoccur [4]. Careful consideration should be given to distinguish breast ACC from conditions that may appear histologically similar, including invasive cribriform carcinoma and collagenous spherulosis [4, 5]. This can be achieved through immunohistochemistry as invasive cribriform carcinoma of the breast is typically ER and PR positive and negative for c-KIT and p63 markers [4]. Collagenous spherulosis is typically c-KIT and myosin negative compared to ACC, which is c-KIT and myosin positive [4].
The standard of care for breast ACC is based on the grade of the tumor [3]. For grade 1, wide local excision is recommended; for grade 2, simple mastectomy is recommended and for grade 3, mastectomy with axillary lymph node dissection is recommended [3]. Although some have indicated that lymph node involvement is uncommon and, therefore, resection is unnecessary, others have suggested that it may benefit high-grade tumors [2, 7, 8]. A modified radical mastectomy was performed in our patient’s case, and the patient refused adjuvant chemotherapy and radiotherapy. In contrast to other triple-negative breast cancers, ACC tends to have a relatively good prognosis [1]. Although distant metastases are uncommon, they have been described with and without nodal involvement [1]. When metastasis does occur, it is common in women who underwent wide local excision alone, although it has also been described in women who underwent a mastectomy, as in our patient [5]. The role of adjuvant radiation therapy is not yet fully elucidated, although multiple studies have reported that radiation improves the survival of patients [9, 10]. The 10-year survival rate of breast ACC has been reported as 85–100%, with the rate of lymph node metastasis occurring in less than 2% of cases [5, 10].
CONCLUSIONS
Breast ACC is a rare subtype of triple-negative breast cancer with a favorable prognosis. There is no clear consensus on the most appropriate treatment of breast ACC at this time, and although the rate of metastasis is low, it has been seen more commonly in cases of local excision than mastectomy. Immunohistochemistry of these cancers plays an essential role in differentiating it from masses that share similar histology and identifying metastatic lesions when they occur. The role of radiation therapy is also unclear at this point, but studies suggest survival benefit in patients who receive adjuvant radiotherapy.